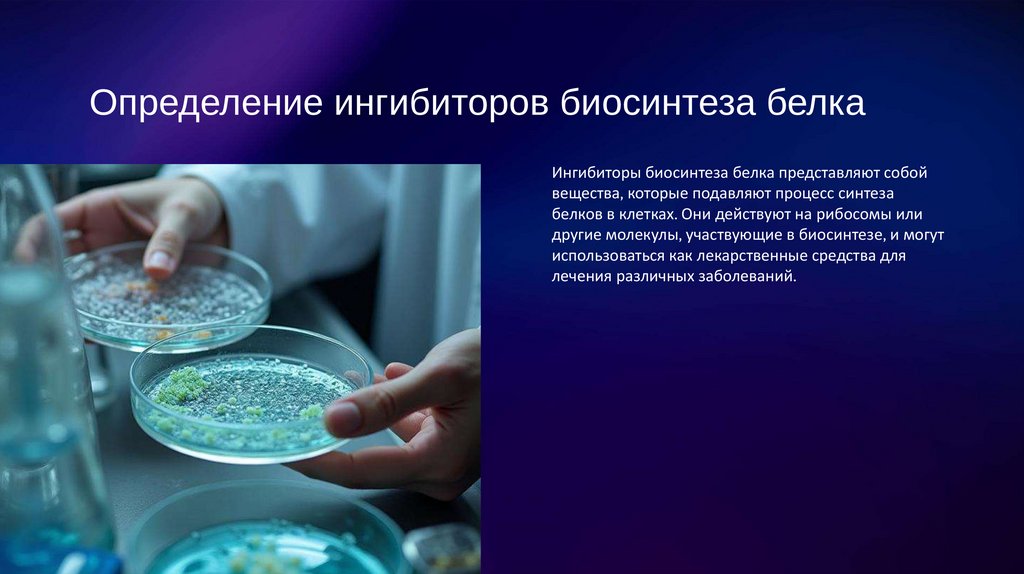

Похожие презентации:
Ингибиторы. Изучение ингибиторов биосинтеза белка и их значимость в медицине
1.
ИнгибиторыИзучение ингибиторов биосинтеза
белка и их значимость в медицине
2.
ВведениеДанная презентация освещает ключевые аспекты
ингибиторов биосинтеза белка, их классификацию,
применение и роль в медицинской практике.
3.
01Введение
4.
Определение ингибиторов биосинтеза белкаИнгибиторы биосинтеза белка представляют собой
вещества, которые подавляют процесс синтеза
белков в клетках. Они действуют на рибосомы или
другие молекулы, участвующие в биосинтезе, и могут
использоваться как лекарственные средства для
лечения различных заболеваний.
5.
Роль в медицинеИнгибиторы биосинтеза белка играют важную роль в конгломерации лечения
инфекционных заболеваний, включая бактериальные, вирусные и опухолевые.
Они являются основными компонентами антимикробной терапии.
6.
02Классификация
7.
Типы ингибиторовСуществуют различные классы ингибиторов
биосинтеза белка, которые могут быть разделены на
антибактериальные, противовирусные и
противоопухолевые. Каждый класс имеет свои
механизмы действия и применение.
8.
Примеры9.
Одним из мощных ингибиторов белкового синтеза является пуромицин (смрисунок 2). Из-за структурного сходства его с концевым остатком адениловой
кислоты в аминоацил-тРНК он легко взаимодействует с пептидил-тРНК с
образованием пептидил-пуромицина. Поскольку пептидил-пуромицин не
несет на себе триплета антикодона, он тем самым тормозит элонгацию
пРптидной цепи, вызывая обрыв реакции. Затем свободные пептидилпуромицины освобождаются из рибосомы. При помощи пуромицина было
доказано, например, что гормональный эффект в ряде случаев зависит от
синтеза белка de novo. Белковый синтез тормозится актиномицином D,
обладающим противоопухолевым эффектом, но вследствие высокой токсичности применяется редко. Он оказывает тормозящее влияние на синтез всех
типов клеточной РНК, в особенности мРНК. Это свойство вызвано тормозящим
влиянием актиномицина D на ДНК-зависимую РНК-полимеразу, поскольку он
связывается с остатками дезоксигуанозина цепи ДНК, выключая матричную
функцию последней. Можно считать, что актиномицин ингибирует
транскрипцию ДНК.
10.
03Применение
11.
Лечение инфекционных заболеванийИнгибиторы биосинтеза белка часто применяются
для лечения бактериальных инфекций, таких как
пневмония, менингит и туберкулез. Они действуют,
блокируя синтез белков у микроорганизмов.
12.
ХимиотерапияВ онкологической практике некоторые ингибиторы биосинтеза белка
используются для подавления роста опухолей, воздействуя на механизм
синтеза белка в раковых клетках.
13.
04Исследования
14.
Современные подходыСовременные исследования направлены на разработку новых ингибиторов и
молекул, которые могут обойти механизмы резистентности, улучшая
терапевтические результаты.
15.
Клинические испытанияМногочисленные клинические испытания проводятся для оценки
эффективности новых ингибиторов и их комбинаций с другими средствами для
улучшения лечения инфекций.
16.
ЗаключениеИнгибиторы биосинтеза белка продолжают играть
ведущую роль в медицине, несмотря на
возникающие проблемы, и их дальнейшие
исследования могут существенно изменить подходы
к лечению.

Биология
Биология








